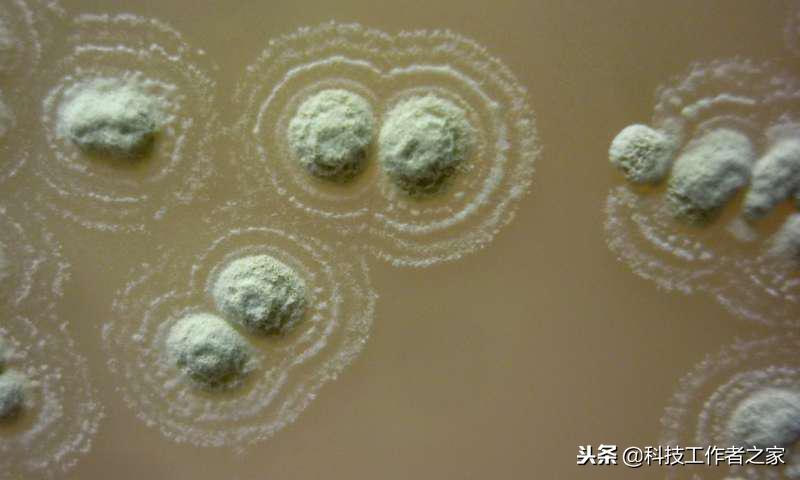
抗细菌最好的克星,超级细菌的克星有哪些

新发现的链霉菌可散发出类似冬青油的独特气味。尽管链霉菌看起来像真菌,但却是不折不扣的细菌,并且是约三分之二的抗生素的来源。

新链霉菌在耐甲氧西林金黄色葡萄球菌菌苔上产生的抑菌圈。
phys.org网站12月27日报道,研究人员通过分析长期以来被认为具有药用价值的爱尔兰土壤,发现了一种新的细菌菌株,这种菌株对六大耐抗生素超级细菌中的4种有良好的抑制作用。
最新研究预测,到2050年,超级细菌或可导致欧洲上百万人死亡。世界卫生组织(WHO)认为 “耐药超级细菌问题是对全球卫生、食品安全和发展的最大威胁之一”。来自威尔士、巴西、伊拉克和北爱尔兰的研究人员在英国斯旺西大学医学院(Swansea University)发现了一种新型链霉菌,并将其命名为sp. myrophorea。他们分析的土壤来自北爱尔兰弗马纳地区(即波西米亚高地)。这一地区属于碱性草地,其土壤被认为具有良好的治疗性能。为了对抗多重耐药性,寻找抗生素替代品,研究人员开始对新的药物领域(如民族药理学等)展开研究。研究小组成员之一,格里奎因博士(Dr. Gerry Quinn)曾是波西米亚高地的居民,他对该地区的治疗传统有所了解——人们用棉布裹上少量泥土,用于治疗牙痛和喉咙感染等多种疾病。
研究人员发现,在世界卫生组织确定的六大耐多药病原体中,有4种病菌的生长受到了新发现的链霉菌菌株的抑制。这4种超级细菌分别是:万古霉素耐药肠球菌(VRE)、耐甲氧西林金黄色葡萄球菌(MRSA)、克雷伯菌肺炎和卡比尼培南耐药鲍曼不动杆菌。新型链霉菌对革兰氏阳性菌和革兰氏阴性菌均有抑制效果。虽然目前还不清楚这种新菌株的具体抑菌成分,但研究小组已经对此展开了研究。斯旺西大学医学院的保罗·戴森教授(Prof. Paul Dyson)说:“这种新菌株对4种超级细菌有效,我们的发现将为对抗抗生素耐药性产生重要影响。”新链霉菌的结果表明,对寻找新抗生素而言,民间传说和传统药物都是值得研究的。科学家、历史学家和考古学家都可以在这项工作中有所贡献。格里奎因博士补充说:“目前,我们将集中研究这类抗生素的纯化和鉴定。此外,我们还从同一种土壤中发现了其他多种抗菌微生物,这些微生物可能包含更广泛的耐多药病原体。”
编译:雷鑫宇
责编:南熙